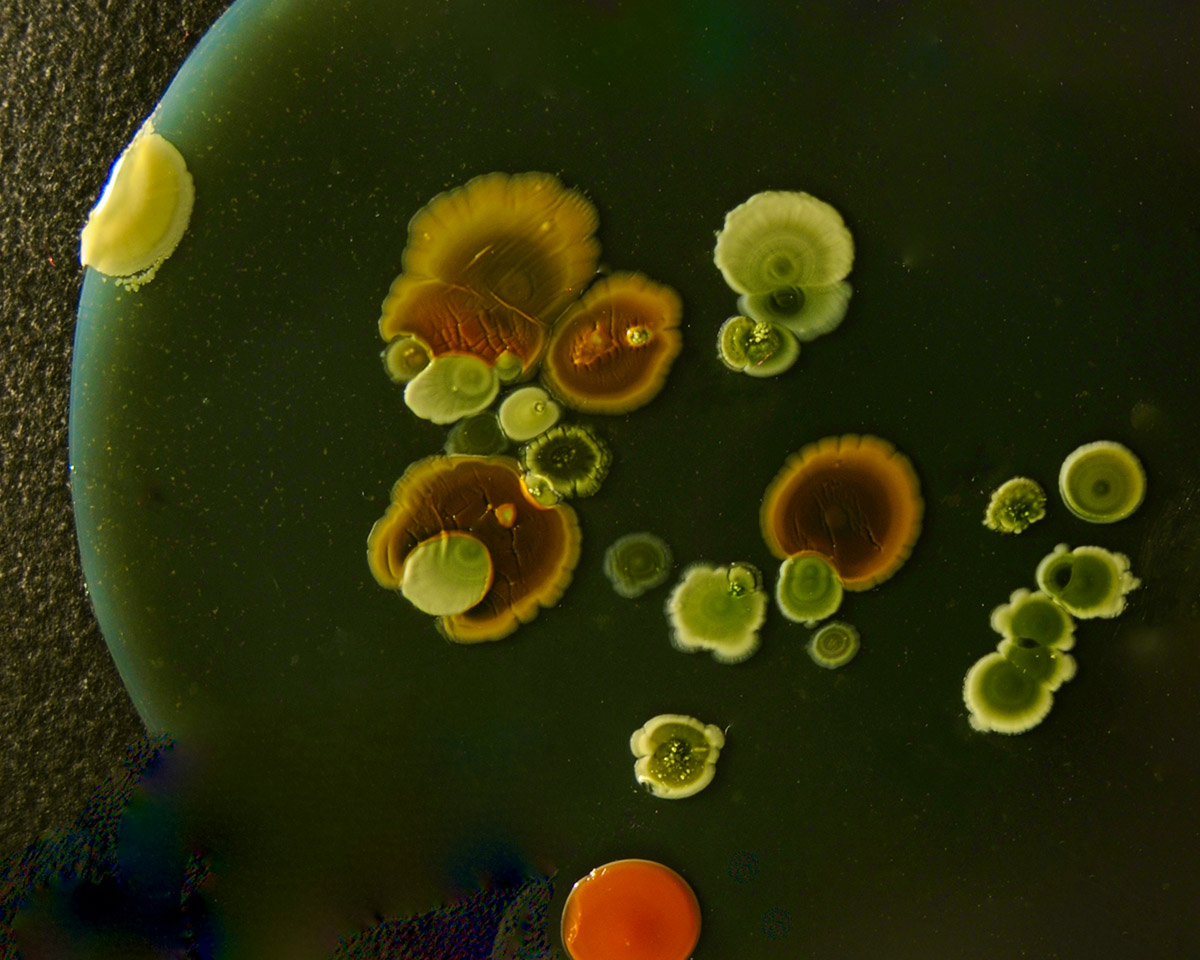
Batteri per le piante: cosa cambia con i biostimolanti microbici

Piante che non producono fiori: quali sono e come riconoscerle
Quando si parla di “piante che non producono fiori” spesso si pensa a un mondo “più semplice” rispetto alle piante ornamentali classiche. In realtà è un universo ricchissimo, con strategie di riproduzione diverse e un’enorme varietà di forme, texture e colori di verde. Capire quali piante non fioriscono davvero (e perché) aiuta a scegliere meglio cosa coltivare in casa, in terrazzo o in giardino, evitando aspettative sbagliate e ottenendo risultati più soddisfacenti. Sommario Cosa vuol dire “piante che non producono fiori” Dire che una pianta “non produce fiori” significa, in senso botanico, che non appartiene alle angiosperme, cioè alle piante…